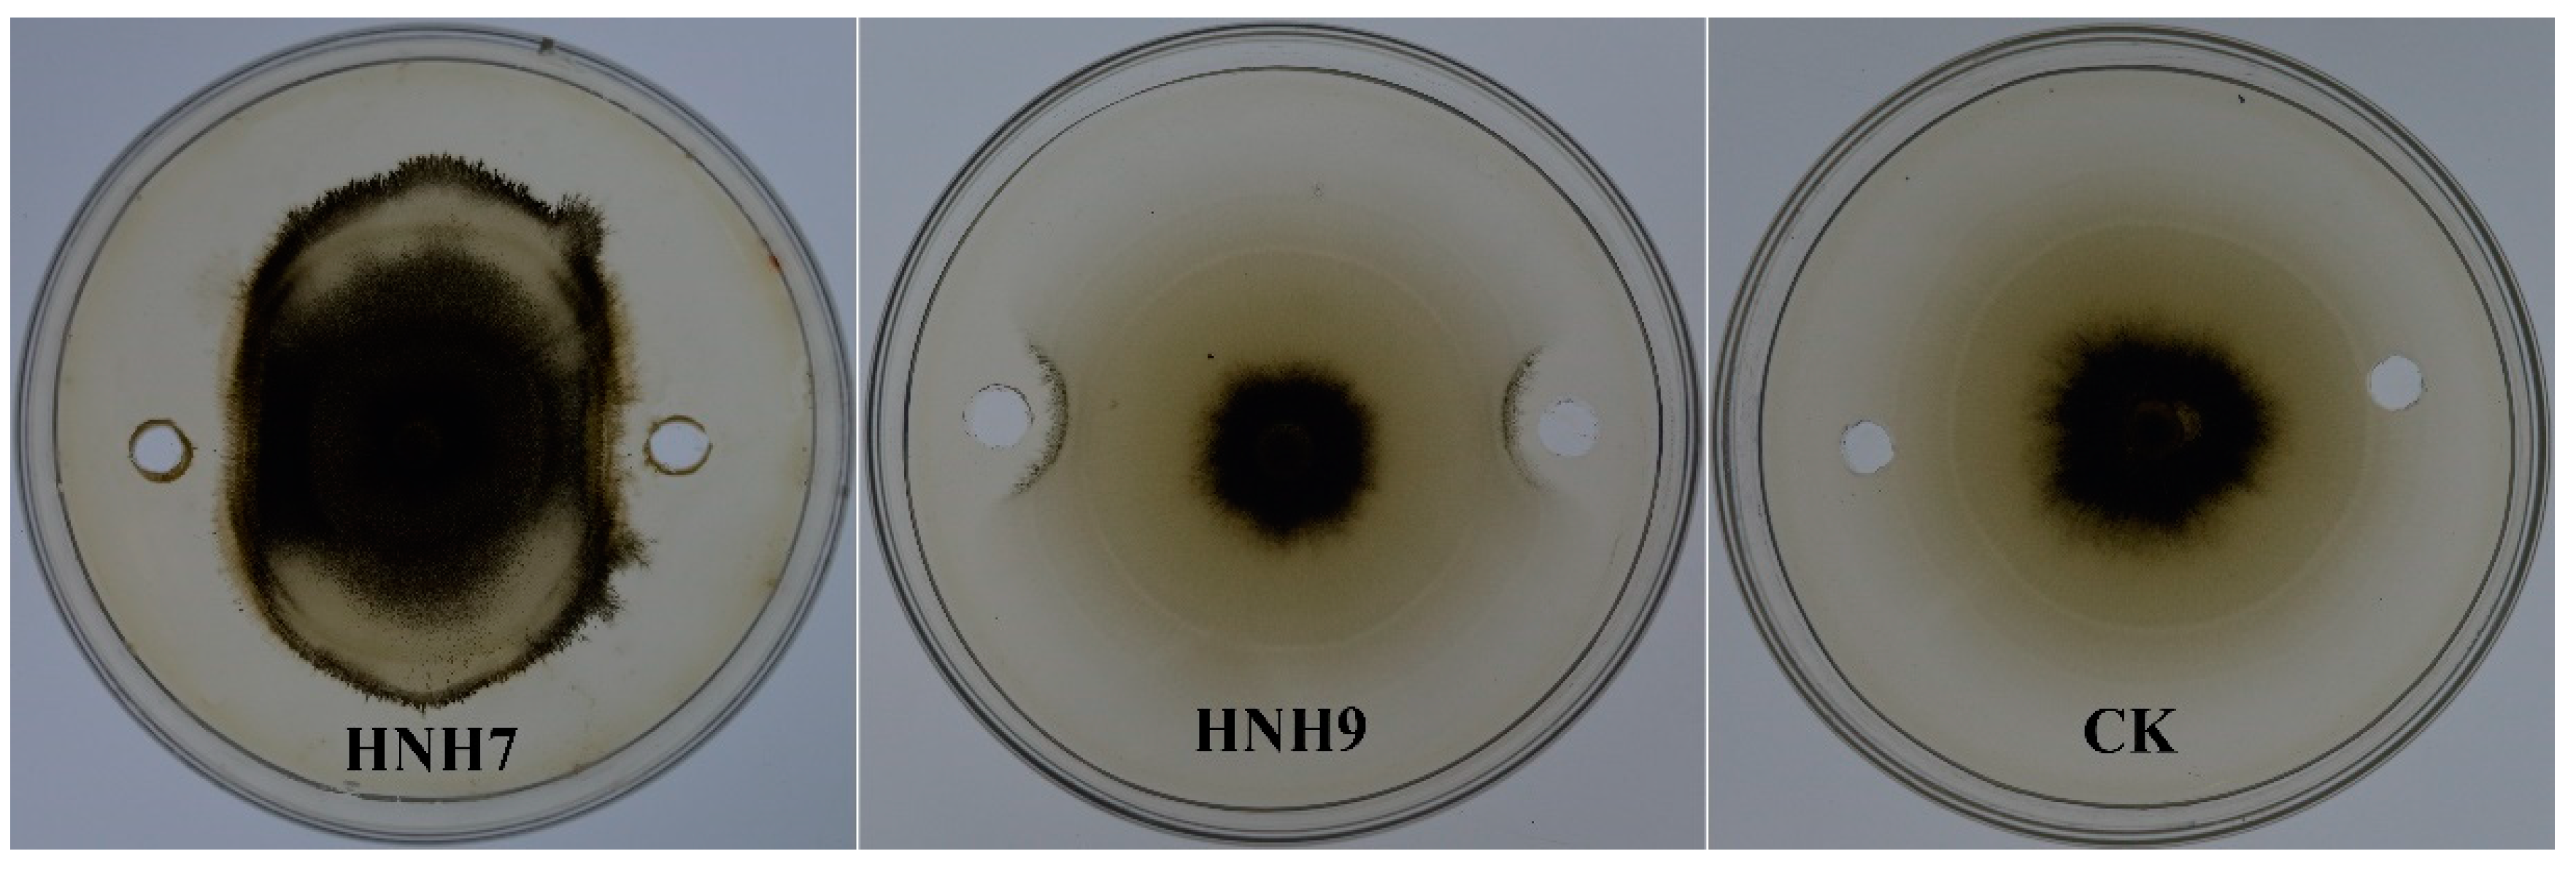
Plants 09 01438 g003 Plants 09 01438 g003

Antagonistic Potential of Novel Endophytic Bacillus Strains and Mediation of Plant Defense against Verticillium Wilt in Upland Cotton
Abstract
1. Introduction
2. Results
2.1. Identification and Phylogenetic Analysis of Bacterial Endophytes
2.2. Antagonistic Activity of the Bacterial Isolates against VD-080
2.3. Interaction of Extracted Lipopeptides (LPs) with VD-080
2.4. PCR-Based Detection of LPs Encoded Genes
2.5. LC-MS Analysis of Antimicrobial Compounds
2.6. Hyphal Anomalies in VD-080 by Methanolic Extracts of Endophytic Bacillus Strains
2.7. Biocontrol Effects of the Isolates on Cotton Verticillium Wilt
2.8. Expression Profiling of Plant Defense-Linked Genes
3. Discussion
4. Materials and Methods
4.1. Isolation of Endophytic Bacterial Isolates
4.2. 16S rDNA Identification
4.3. Antagonistic Activity of Endophytes against V. dahliae (VD-080)
4.4. Antifungal Activity of Secondary Metabolites
4.5. Identification of Antifungal Genes Using Molecular Markers
4.6. LC-MS Analysis of Antimicrobial Compounds
4.7. Scanning Electron Microscopy
4.8. Biocontrol Effects of Endophytes in Greenhouse Experiment
4.9. Expression Analysis of Defense-Linked Genes in Cotton Plants through qRT-PCR
4.10. Statistical Analysis
5. Conclusions
Author Contributions
Funding
Acknowledgments
Conflicts of Interest
References
- Wang, Y.; Liang, C.; Wu, S.; Zhang, X.; Tang, J.; Jian, G.; Jiao, G.; Li, F.; Chu, C. Significant improvement of cotton Verticillium wilt resistance by manipulating the expression of Gastrodia antifungal proteins. Mol. Plant 2016, 9, 1436–1439. [Google Scholar] [CrossRef] [PubMed]
- Zhang, K.; Pei, Z.; Hongmei, W.; Yunlei, Z.; Wei, C.; Haiyan, G.; Xiaohui, S.; Yanli, C. Isolation and characterization of the GbVIP1 gene and response to Verticillium wilt in cotton and tobacco. J. Cotton Res. 2019, 2, 2. [Google Scholar] [CrossRef]
- Goicoechea, N. To what extent are soil amendments useful to control Verticillium wilt? Pest Manag. Sci. Former. Pestic. Sci. 2009, 65, 831–839. [Google Scholar] [CrossRef] [PubMed]
- Berg, G.; Hallmann, J. Control of plant pathogenic fungi with bacterial endophytes. In Microbial Root Endophytes; Springer: Berlin/Heidelberg, Germany, 2006; pp. 53–69. [Google Scholar]
- Chen, L.; Shi, H.; Heng, J.; Wang, D.; Bian, K. Antimicrobial, plant growth-promoting and genomic properties of the peanut endophyte Bacillus velezensis LDO2. Microbiol. Res. 2019, 218, 41–48. [Google Scholar] [CrossRef]
- Han, Q.; Wu, F.; Wang, X.; Qi, H.; Shi, L.; Ren, A.; Liu, Q.; Zhao, M.; Tang, C. The bacterial lipopeptide iturins induce V erticillium dahliae cell death by affecting fungal signalling pathways and mediate plant defence responses involved in pathogen-associated molecular pattern-triggered immunity. Environ. Microbiol. 2015, 17, 1166–1188. [Google Scholar] [CrossRef]
- Li, B.; Li, Q.; Xu, Z.; Zhang, N.; Shen, Q.; Zhang, R. Responses of beneficial Bacillus amyloliquefaciens SQR9 to different soilborne fungal pathogens through the alteration of antifungal compounds production. Front. Microbiol. 2014, 5, 636. [Google Scholar] [CrossRef]
- Li, C.H.; Shi, L.; Han, Q.; Hu, H.L.; Zhao, M.W.; Tang, C.M.; Li, S.P. Biocontrol of Verticillium wilt and colonization of cotton plants by an endophytic bacterial isolate. J. Appl. Microbiol. 2012, 113, 641–651. [Google Scholar] [CrossRef]
- Zhang, F.; Li, X.-L.; Zhu, S.-J.; Ojaghian, M.R.; Zhang, J.-Z. Biocontrol potential of Paenibacillus polymyxa against Verticillium dahliae infecting cotton plants. Biol. Control 2018, 127, 70–77. [Google Scholar] [CrossRef]
- Hanif, A.; Zhang, F.; Li, P.; Li, C.; Xu, Y.; Zubair, M.; Zhang, M.; Jia, D.; Zhao, X.; Liang, J. Fengycin produced by Bacillus amyloliquefaciens FZB42 inhibits Fusarium graminearum growth and mycotoxins biosynthesis. Toxins 2019, 11, 295. [Google Scholar] [CrossRef]
- Hussein, W.; Awad, H.; Fahim, S. Systemic resistance induction of tomato plants against ToMV virus by surfactin produced from Bacillus subtilis BMG02. Am. J. Microbiol. Res. 2016, 4, 153–158. [Google Scholar]
- Lu, X.; Zhou, D.; Chen, X.; Zhang, J.; Huang, H.; Wei, L. Isolation and characterization of Bacillus altitudinis JSCX-1 as a new potential biocontrol agent against Phytophthora sojae in soybean [Glycine max (L.) Merr.]. Plant Soil 2017, 416, 53–66. [Google Scholar] [CrossRef]
- Nicholson, W. Roles of Bacillus endospores in the environment. Cell. Mol. Life Sci. CMLS 2002, 59, 410–416. [Google Scholar] [CrossRef] [PubMed]
- Compant, S.; Duffy, B.; Nowak, J.; Clément, C.; Barka, E.A. Use of plant growth-promoting bacteria for biocontrol of plant diseases: Principles, mechanisms of action, and future prospects. Appl. Environ. Microbiol. 2005, 71, 4951–4959. [Google Scholar] [CrossRef] [PubMed]
- Farzand, A.; Moosa, A.; Zubair, M.; Khan, A.R.; Hanif, A.; Tahir, H.A.S.; Gao, X. Marker assisted detection and LC-MS analysis of antimicrobial compounds in different Bacillus strains and their antifungal effect on Sclerotinia sclerotiorum. Biol. Control 2019, 133, 91–102. [Google Scholar] [CrossRef]
- Koumoutsi, A.; Chen, X.-H.; Henne, A.; Liesegang, H.; Hitzeroth, G.; Franke, P.; Vater, J.; Borriss, R. Structural and functional characterization of gene clusters directing nonribosomal synthesis of bioactive cyclic lipopeptides in Bacillus amyloliquefaciens strain FZB42. J. Bacteriol. 2004, 186, 1084–1096. [Google Scholar] [CrossRef] [PubMed]
- Chen, X.-H.; Vater, J.; Piel, J.; Franke, P.; Scholz, R.; Schneider, K.; Koumoutsi, A.; Hitzeroth, G.; Grammel, N.; Strittmatter, A.W. Structural and functional characterization of three polyketide synthase gene clusters in Bacillus amyloliquefaciens FZB 42. J. Bacteriol. 2006, 188, 4024–4036. [Google Scholar] [CrossRef]
- Duan, C.; Yu, J.; Bai, J.; Zhu, Z.; Wang, X. Induced defense responses in rice plants against small brown planthopper infestation. Crop J. 2014, 2, 55–62. [Google Scholar] [CrossRef]
- Farzand, A.; Moosa, A.; Zubair, M.; Khan, A.R.; Massawe, V.C.; Tahir, H.A.S.; Sheikh, T.M.M.; Ayaz, M.; Gao, X. Suppression of Sclerotinia sclerotiorum by the Induction of Systemic Resistance and Regulation of Antioxidant Pathways in Tomato Using Fengycin Produced by Bacillus amyloliquefaciens FZB42. Biomolecules 2019, 9, 613. [Google Scholar] [CrossRef]
- Rais, A.; Jabeen, Z.; Shair, F.; Hafeez, F.Y.; Hassan, M.N. Bacillus spp., a bio-control agent enhances the activity of antioxidant defense enzymes in rice against Pyricularia oryzae. PLoS ONE 2017, 12, e0187412. [Google Scholar] [CrossRef]
- Sahu, P.K.; Singh, S.; Gupta, A.; Singh, U.B.; Brahmaprakash, G.; Saxena, A.K. Antagonistic potential of bacterial endophytes and induction of systemic resistance against collar rot pathogen Sclerotium rolfsii in tomato. Biol. Control 2019, 137, 104014. [Google Scholar] [CrossRef]
- López-Escudero, F.J.; Mercado-Blanco, J. Verticillium wilt of olive: A case study to implement an integrated strategy to control a soil-borne pathogen. Plant Soil 2011, 344, 1–50. [Google Scholar] [CrossRef]
- Beneduzi, A.; Ambrosini, A.; Passaglia, L.M. Plant growth-promoting rhizobacteria (PGPR): Their potential as antagonists and biocontrol agents. Genet. Mol. Biol. 2012, 35, 1044–1051. [Google Scholar] [CrossRef] [PubMed]
- Maksimov, I.; Abizgil’Dina, R.; Pusenkova, L. Plant growth promoting rhizobacteria as alternative to chemical crop protectors from pathogens. Appl. Biochem. Microbiol. 2011, 47, 333–345. [Google Scholar] [CrossRef]
- Qin, Y.; Han, Y.; Yu, Y.; Shang, Q.; Zhang, B.; Li, P. Complete genome sequence of Bacillus amyloliquefaciens L-S60, a plant growth-promoting and antifungal bacterium. J. Biotechnol. 2015, 212, 67–68. [Google Scholar] [CrossRef]
- Massawe, V.C.; Hanif, A.; Farzand, A.; Mburu, D.K.; Ochola, S.O.; Wu, L.; Tahir, H.A.S.; Gu, Q.; Wu, H.; Gao, X. Volatile compounds of endophytic Bacillus spp. have biocontrol activity against Sclerotinia sclerotiorum. Phytopathology 2018, 108, 1373–1385. [Google Scholar] [CrossRef]
- Milijašević-Marčić, S.; Todorović, V.; Stanojević, O.; Berić, T.; Stanković, S.; Todorović, B.; Potočnik, I. Antagonistic potential of Bacillus spp. isolates against bacterial pathogens of tomato and fungal pathogen of pepper. Pestic. I Fitomedicina 2018, 33, 9–18. [Google Scholar] [CrossRef]
- Joshi, R.; McSpadden Gardener, B.B. Identification and characterization of novel genetic markers associated with biological control activities in Bacillus subtilis. Phytopathology 2006, 96, 145–154. [Google Scholar] [CrossRef]
- Stein, T. Bacillus subtilis antibiotics: Structures, syntheses and specific functions. Mol. Microbiol. 2005, 56, 845–857. [Google Scholar] [CrossRef] [PubMed]
- Romero-Tabarez, M.; Jansen, R.; Sylla, M.; Lünsdorf, H.; Häußler, S.; Santosa, D.A.; Timmis, K.N.; Molinari, G. 7-O-malonyl macrolactin A, a new macrolactin antibiotic from Bacillus subtilis active against methicillin-resistant Staphylococcus aureus, vancomycin-resistant enterococci, and a small-colony variant of Burkholderia cepacia. Antimicrob. Agents Chemother. 2006, 50, 1701–1709. [Google Scholar] [CrossRef]
- Farzand, A.; Moosa, A.; Zubair, M.; Khan, A.R.; Ayaz, M.; Massawe, V.C.; Gao, X. Transcriptional Profiling of Diffusible Lipopeptides and Fungal Virulence Genes During Bacillus amyloliquefaciens EZ1509-Mediated Suppression of Sclerotinia sclerotiorum. Phytopathology 2020, 110, 317–326. [Google Scholar] [CrossRef]
- Romero, D.; De Vicente, A.; Olmos, J.; Dávila, J.; Pérez-García, A. Effect of lipopeptides of antagonistic strains of Bacillus subtilis on the morphology and ultrastructure of the cucurbit fungal pathogen Podosphaera fusca. J. Appl. Microbiol. 2007, 103, 969–976. [Google Scholar]
- Vitullo, D.; Di Pietro, A.; Romano, A.; Lanzotti, V.; Lima, G. Role of new bacterial surfactins in the antifungal interaction between Bacillus amyloliquefaciens and Fusarium oxysporum. Plant Pathol. 2012, 61, 689–699. [Google Scholar]
- Chandrasekaran, M.; Chun, S.C. Expression of PR-protein genes and induction of defense-related enzymes by Bacillus subtilis CBR05 in tomato (Solanum lycopersicum) plants challenged with Erwinia carotovora subsp. carotovora. Biosci. Biotechnol. Biochem. 2016, 80, 2277–2283. [Google Scholar]
- Li, Y.; Gu, Y.; Li, J.; Xu, M.; Wei, Q.; Wang, Y. Biocontrol agent Bacillus amyloliquefaciens LJ02 induces systemic resistance against cucurbits powdery mildew. Front. Microbiol. 2015, 6, 883. [Google Scholar]
- Alscher, R.G.; Erturk, N.; Heath, L.S. Role of superoxide dismutases (SODs) in controlling oxidative stress in plants. J. Exp. Bot. 2002, 53, 1331–1341. [Google Scholar]
- Li, L.; Steffens, J.C. Overexpression of polyphenol oxidase in transgenic tomato plants results in enhanced bacterial disease resistance. Planta 2002, 215, 239–247. [Google Scholar]
- Pitzschke, A.; Schikora, A.; Hirt, H. MAPK cascade signalling networks in plant defence. Curr. Opin. Plant Biol. 2009, 12, 421–426. [Google Scholar]
- Lu, K.; Guo, W.; Lu, J.; Yu, H.; Qu, C.; Tang, Z.; Li, J.; Chai, Y.; Liang, Y. Genome-wide survey and expression profile analysis of the mitogen-activated protein kinase (MAPK) gene family in Brassica rapa. PLoS ONE 2015, 10, e0132051. [Google Scholar]
- Beckers, G.J.; Jaskiewicz, M.; Liu, Y.; Underwood, W.R.; He, S.Y.; Zhang, S.; Conrath, U. Mitogen-activated protein kinases 3 and 6 are required for full priming of stress responses in Arabidopsis thaliana. Plant Cell 2009, 21, 944–953. [Google Scholar]
- Nianiou-Obeidat, I.; Madesis, P.; Kissoudis, C.; Voulgari, G.; Chronopoulou, E.; Tsaftaris, A.; Labrou, N.E. Plant glutathione transferase-mediated stress tolerance: Functions and biotechnological applications. Plant Cell Rep. 2017, 36, 791–805. [Google Scholar]
- Dalton, D.A.; Boniface, C.; Turner, Z.; Lindahl, A.; Kim, H.J.; Jelinek, L.; Govindarajulu, M.; Finger, R.E.; Taylor, C.G. Physiological roles of glutathione S-transferases in soybean root nodules. Plant Physiol. 2009, 150, 521–530. [Google Scholar] [CrossRef]
- Sharma, R.; Sahoo, A.; Devendran, R.; Jain, M. Over-expression of a rice tau class glutathione s-transferase gene improves tolerance to salinity and oxidative stresses in Arabidopsis. PLoS ONE 2014, 9, e92900. [Google Scholar] [CrossRef]
- Chappell, J. Biochemistry and molecular biology of the isoprenoid biosynthetic pathway in plants. Annu. Rev. Plant Biol. 1995, 46, 521–547. [Google Scholar] [CrossRef]
- Latif Khan, A.; Ahmed Halo, B.; Elyassi, A.; Ali, S.; Al-Hosni, K.; Hussain, J.; Al-Harrasi, A.; Lee, I.-J. Indole acetic acid and ACC deaminase from endophytic bacteria improves the growth of Solarium lycopersicum. Electron. J. Biotechnol. 2016, 19, 58–64. [Google Scholar]
- Phillips, K.; Zaidan, F.; Elizondo, O.R.; Lowe, K.L. Phenotypic characterization and 16S rDNA identification of culturable non-obligate halophilic bacterial communities from a hypersaline lake, La Sal del Rey, in extreme South Texas (USA). Aquat. Biosyst. 2012, 8, 5. [Google Scholar] [CrossRef]
- Wu, L.; Wu, H.; Chen, L.; Xie, S.; Zang, H.; Borriss, R.; Gao, X. Bacilysin from Bacillus amyloliquefaciens FZB42 has specific bactericidal activity against harmful algal bloom species. Appl. Environ. Microbiol. 2014, 80, 7512–7520. [Google Scholar] [CrossRef]
- Kumar, S.; Stecher, G.; Li, M.; Knyaz, C.; Tamura, K. MEGA X: Molecular evolutionary genetics analysis across computing platforms. Mol. Biol. Evol. 2018, 35, 1547–1549. [Google Scholar] [CrossRef]
- Tamura, K.; Nei, M. Estimation of the number of nucleotide substitutions in the control region of mitochondrial DNA in humans and chimpanzees. Mol. Biol. Evol. 1993, 10, 512–526. [Google Scholar]
- Sarwar, A.; Brader, G.; Corretto, E.; Aleti, G.; Abaidullah, M.; Sessitsch, A.; Hafeez, F.Y. Qualitative analysis of biosurfactants from Bacillus species exhibiting antifungal activity. PLoS ONE 2018, 13, e0198107. [Google Scholar]
- Ramarathnam, R.; Bo, S.; Chen, Y.; Fernando, W.D.; Xuewen, G.; De Kievit, T. Molecular and biochemical detection of fengycin-and bacillomycin D-producing Bacillus spp., antagonistic to fungal pathogens of canola and wheat. Can. J. Microbiol. 2007, 53, 901–911. [Google Scholar] [CrossRef]
- Hajji, M.; Jarraya, R.; Lassoued, I.; Masmoudi, O.; Damak, M.; Nasri, M. GC/MS and LC/MS analysis, and antioxidant and antimicrobial activities of various solvent extracts from Mirabilis jalapa tubers. Process Biochem. 2010, 45, 1486–1493. [Google Scholar] [CrossRef]
- Gu, Q.; Yang, Y.; Yuan, Q.; Shi, G.; Wu, L.; Lou, Z.; Huo, R.; Wu, H.; Borriss, R.; Gao, X. Bacillomycin D produced by Bacillus amyloliquefaciens is involved in the antagonistic interaction with the plant-pathogenic fungus Fusarium graminearum. Appl. Environ. Microbiol. 2017, 83, e01075-17. [Google Scholar] [CrossRef]
- Idris, H.A.; Labuschagne, N.; Korsten, L. Screening rhizobacteria for biological control of Fusarium root and crown rot of sorghum in Ethiopia. Biol. Control 2007, 40, 97–106. [Google Scholar] [CrossRef]
- Bawa, G.; Feng, L.; Li, Y.; Shang, J.; Wu, X.; Chang, X.; Sun, X.; Yu, L.; Liu, C.; Du, J. Physiological Analysis Reveals the Possible Resistance Mechanisms of Glycine max to Fusarium solani. J. Agric. Sci. 2018, 10, 44–56. [Google Scholar] [CrossRef][Green Version]
- NCBI. Available online: https://www.ncbi.nlm.nih.gov. (accessed on 7 November 2019).
- Livak, K.J.; Schmittgen, T.D. Analysis of relative gene expression data using real-time quantitative PCR and the 2− ΔΔCT method. Methods 2001, 25, 402–408. [Google Scholar] [CrossRef] [PubMed]
B. amyloliquefaciens, 2 =
B. velezensis, 3 =
B. subtilis, 4 =
B. pumilus, 5 =
B. altitudinis, 6 =
B. aryabhattai.
B. amyloliquefaciens, 2 =
B. velezensis, 3 =
B. subtilis, 4 =
B. pumilus, 5 =
B. altitudinis, 6 =
B. aryabhattai.

| Endophytic Bacillus Strains | Inhibition Zone (mm) |
|---|---|
| B. aryabhattai HNH1 | 7.1 ± 0.11 d |
| B. subtilis HNH2 | 7.0 ± 0.10 d |
| B. subtilis HNH3 | 7.7 ± 0.10 c |
| B. amyloliquefaciens HNH4 | 7.6 ± 0.06 c |
| B pumilus HNH5 | 5.0 ± 0.09 f |
| B. subtilis HNH6 | 6.9 ± 0.07 d |
| B. altitudinis HNH7 | 10.5 ± 0.07 a |
| B. amyloliquefaciens HNH8 | 5.9 ± 0.09 e |
| B. velezensis HNH9 | 9.3 ± 0.09 b |
| *CK | 0.0 ± 0.00 g |
| Product | Gene | Temp (°C) | Primer Sequences | Size (bp) | Reference |
|---|---|---|---|---|---|
| Bacillibectin | BAC | 57.6 | ATCTTTATGGCGGCAGTC ATACGGCTTACAGGCGAG | 595 | [15] |
| Bacillomycin | BMYB | 55.3 | CGAAACGACGGTATGAAT TCTGCCGTTCCTTATCTC | 371 | [15] |
| Iturin | ITUB | 55.1 | ATCACCGATTCGATTTCA GCTCGCTCCATATTATTTC | 708 | [15] |
| Surfactin | SFB | 50.0 | TTCACACAATTAGAGCT ATATGATGATTGCTCCAG | 338 | [15] |
| Fengycin | FEND | 57.6 | TCAGCCGGTCTGTTGAAG TCCTGCAGAAGGAGAAGT | 231 | [15] |
| No. | Name | Code | Primers (5′ to 3′) |
|---|---|---|---|
| 1 | 3-hydroxy-3-methylglutaryl-coenzyme A reductase | HMGR-F | GTTACAACCGAGGAAGACGAG |
| HMGR-R | CAATGGCAAACCCGATAACG | ||
| 2 | Mitogen-activated protein kinase 3 | MPK3-F | AAATACCCTAAGCCATCCACC |
| MPK3-R | CCAACCCAATTCCCATTTGTG | ||
| 3 | Glutathione-S-transferase | GST-F | TCAGTGCTTTCCTACCCTTTG |
| GST-R | ATACCCAACAGAGCTAGCAAC | ||
| 4 | Phenylalanine ammonia-lyase | PAL-F | ATGTTTGCTCAGTTTTCGGAAC |
| PAL-R | GGCACTTTGAACATGGTTGG | ||
| 5 | Polyphenol oxidase | PPO-F | GAGTCAAGGTTCGTGATAGCC |
| PPO-R | GGTGATGTTCTTTGTTTCGGC | ||
| 6 | Superoxide dismutase | SOD-F | CTGCCTCTGTCTCGATCATTG |
| SOD-R | ACCTTTCTGAATAGCCTCATGG | ||
| 7 | Actin | Actin-F | CGAGACATTGGGACAGGTATTG |
| Actin-R | GAGATCACGACCAGCAAGG |
Publisher’s Note: MDPI stays neutral with regard to jurisdictional claims in published maps and institutional affiliations. |
© 2020 by the authors. Licensee MDPI, Basel, Switzerland. This article is an open access article distributed under the terms and conditions of the Creative Commons Attribution (CC BY) license (http://creativecommons.org/licenses/by/4.0/).
Share and Cite
Hasan, N.; Farzand, A.; Heng, Z.; Khan, I.U.; Moosa, A.; Zubair, M.; Na, Y.; Ying, S.; Canming, T. Antagonistic Potential of Novel Endophytic Bacillus Strains and Mediation of Plant Defense against Verticillium Wilt in Upland Cotton. Plants 2020, 9, 1438. https://doi.org/10.3390/plants9111438
Hasan N, Farzand A, Heng Z, Khan IU, Moosa A, Zubair M, Na Y, Ying S, Canming T. Antagonistic Potential of Novel Endophytic Bacillus Strains and Mediation of Plant Defense against Verticillium Wilt in Upland Cotton. Plants. 2020; 9(11):1438. https://doi.org/10.3390/plants9111438
Chicago/Turabian StyleHasan, Nadeem, Ayaz Farzand, Zhou Heng, Irfan Ullah Khan, Anam Moosa, Muhammad Zubair, Yang Na, Sun Ying, and Tang Canming. 2020. "Antagonistic Potential of Novel Endophytic Bacillus Strains and Mediation of Plant Defense against Verticillium Wilt in Upland Cotton" Plants 9, no. 11: 1438. https://doi.org/10.3390/plants9111438
APA StyleHasan, N., Farzand, A., Heng, Z., Khan, I. U., Moosa, A., Zubair, M., Na, Y., Ying, S., & Canming, T. (2020). Antagonistic Potential of Novel Endophytic Bacillus Strains and Mediation of Plant Defense against Verticillium Wilt in Upland Cotton. Plants, 9(11), 1438. https://doi.org/10.3390/plants9111438
